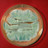
Interaktionen und Nebenwirkungen: Antibiotika Teil 1

Interaktionen und Nebenwirkungen: Johanniskraut
Die Heilpflanze des Jahres 2015 ist ein echter Allrounder: Äußerlich wird Johanniskraut zur Narben- und Hautpflege verwendet, eingenommen kann man ihr einen stimmungsaufhellenden Effekt zuschreiben. Doch auch bei dem gelbblühenden Kraut gibt es einiges in Sachen Neben- und Wechselwirkungen zu beachten.
Wirkungsweise und Dosierung
Johanniskraut und seine Zubereitungen besitzen antidepressive, angstlösende und stimmungsaufhellende Eigenschaften. Innerlich können die Präparate bei Unruhe, Ängstlichkeit, Ein- und Durchschlafstörungen sowie Stimmungsschwankungen bis zur Behandlung von leichten bis mittelschweren depressiven Verstimmungen eingesetzt werden. Empfohlen ist eine Dosierung von 900 mg pro Tag. Unterschiedlich hoch dosierte Präparate sind sowohl als apothekenpflichtige Arzneimittel als auch freiverkäuflich in der Drogerie zu finden. Die Wirkung baut sich zu Beginn der Behandlung auf und erreicht nach etwa 14 Tagen ihr Optimum. Patienten sollten über den verzögerten Wirkeintritt informiert werden, um einen vorzeitigen Therapieabbruch zu vermeiden.
Die antidepressiven, angstlösenden und stimmungsaufhellenden Eigenschaften der Pflanze können auf Hyperforin zurückgeführt werden. Der Inhaltsstoff soll die Wiederaufnahme bestimmter Botenstoffe wie Serotonin und Noradrenalin in die präsynaptische Nervenzelle hemmen und deren Abbau verhindern. Somit wirkt das pflanzliche Präparat wie ein synthetisches Antidepressivum und erhöht die Konzentration an Neurotransmittern im synaptischen Spalt. Außerdem wird eine Hemmung der Monoaminooxidase für den Gesamtextrakt vermutet.
Äußerlich wird das Rotöl zur Haut- und Narbenpflege, in früheren Zeiten auch zur Wundheilung eingesetzt. Flavonoide und Hyperforin sollen hautpflegende, entzündungshemmende und antibakterielle Eigenschaften besitzen. Die im Öl enthaltenen Gerbstoffe sollen eine adstringierende Wirkung haben. Rotöl wird als Haut- und Funktionsöl zur Haut- und Narbenpflege einmasiert und soll das Schießen von wildem Fleisch verhindern. Die Erwärmung des rubinroten Öls auf etwa 40 Grad soll dessen Wirkung verstärken.
Nebenwirkungen und Überdosierung
Die Einnahme von Johanniskraut geht mit einer zunehmenden Photosensibilisierung einher und kann zu sonnenbrandähnlichen Symptomen führen. Vor allem hellhäutige Patienten werden lichtempfindlicher. Zurückzuführen ist die Photosensibilität auf Hypericin. Je höher die Tagesdosis ist, desto höher auch die UV-Lichtempfindlichkeit. Ausgedehnte Sonnenbäder oder das Solarium sollten während der Behandlung vermieden werden. Weitere Nebenwirkungen wie Magen-Darm-Beschwerden, Schwitzen oder Kopfschmerzen sind möglich.
Wechselwirkungen
Johanniskraut ist ein Induktor von CYP450, geht zahlreiche Wechselwirkungen mit anderen Arzneimitteln ein und sollte mit folgenden Wirkstoffen oder Präparaten nicht kombiniert werden:
- Hypericum-Präparate behindern die Wirkung von Blutgerinnungs-Hemmern aus der Gruppe der Vitamin-K-Antagonisten. Diese enthalten die Wirkstoffe Phenprocoumon oder Warfarin. Vitamin K, normalerweise für die Blutgerinnung zuständig, wird durch sie neutralisiert und Blutgerinnsel vermieden. Es wirkt mit bei der Bildung von Gerinnungs-Eiweißen und wird dabei immer wieder verwendet. Die genannten Medikamente unterbrechen diesen Rückbildungsprozess, sodass das aktiv verfügbare Vitamin K in der Menge reduziert wird. Blutproben nach gleichzeitiger Einnahme von Johanniskraut ergaben, dass die Blutgerinnungswerte immens stiegen und die Dosis des Medikaments stark erhöht werden musste, um die notwendige Sicherheit wiederherzustellen. Vermutlich findet auch in diesem Fall die beschleunigte Verarbeitung der Wirkstoffe über die Leber statt.
- Wechselwirkungen sind ebenfalls bei der Kombination mit trizyklischen und anderen Antidepressiva möglich. Vor allem bei Serotonin-Wiederaufnahmehemmern (SRI und SSRI) besteht die Gefahr eines Serotonin-Syndroms. Auch für die gleichzeitige Gabe von Digitoxin, Methadon und hormonellen Kontrazeptiva werden Wechselwirkungen beschrieben. Probleme mit der Empfängnisverhütung durch die Pille sind möglich, da Johanniskraut Zwischenblutungen verursachen kann. Auch bei Theophyllin ergaben Untersuchungen, dass der Wirkstoff unter dem Einfluss von Johanniskraut-Präparaten rascher abgebaut wird, sich infolgedessen nicht mehr ausreichend lange und weniger effektiv zur Vorbeugung und Bekämpfung der Bronchien-Verkrampfung und der entzündlichen Prozesse in den Atemwegen ausbreiten kann.
- Unbedingt mit dem Arzt abzuklären ist eine Einnahme von Johanniskraut, wenn regelmäßig Insulin oder das Diabetes-Medikament Glicazid verabreicht werden muss.
- Auswirkungen hat es auch auf ein Mittel zur Blutfettsenkung, Simvastadin.
- Auch wer nur gelegentlich eine Arznei benötigt, sollte damit rechnen, dass die übliche Acetylsalicyl-Tablette (Aspirin) gegen Kopfschmerzen oder der Magenschutz Omeprazol vollkommen wirkungslos bleiben – was wiederum am beschleunigten Abbau der Wirkstoffe unter Einfluss von Hypericum liegt.
- Auch bei der Einnahme von Immunsuppressiva, wie Ciclosporin, Tacrolimus oder Sirolimus, einigen HIV-Medikamente und angewendeten Zytostatika wie Imatinib oder Irinotecan sollte vor einer Therapie mit Johanniskraut mit dem behandelnden Arzt gesprochen werden.